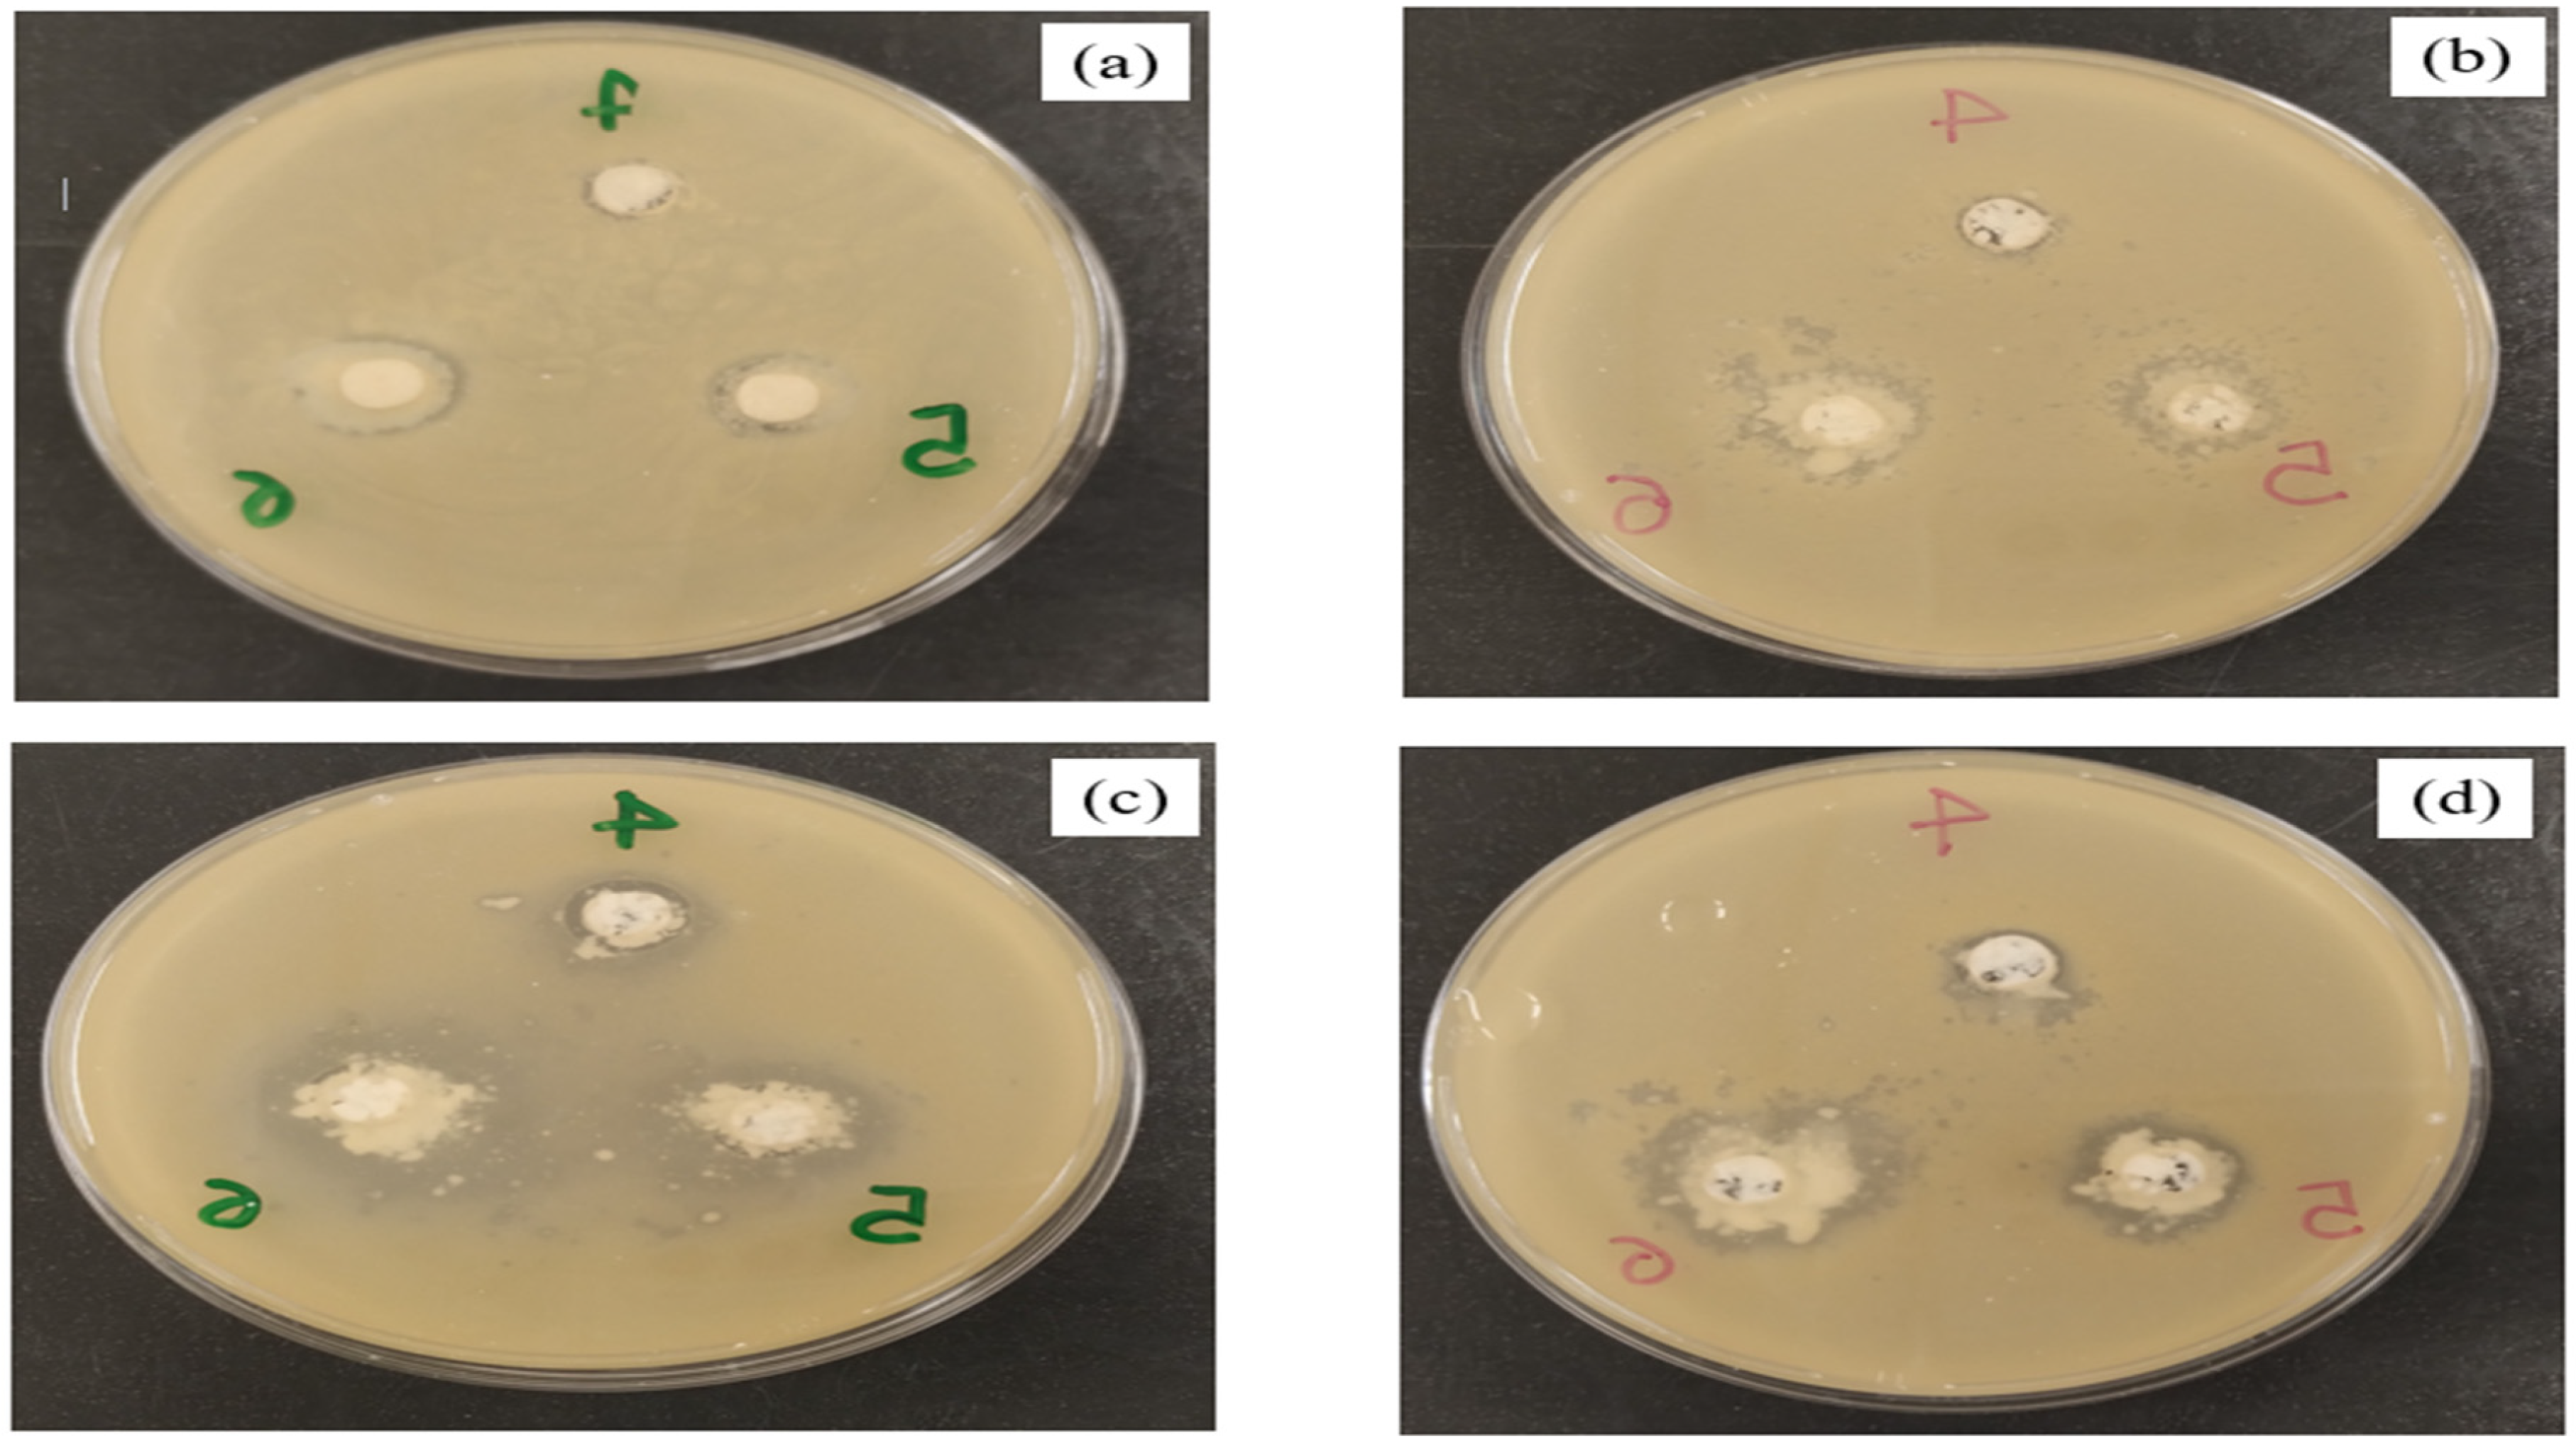
Processes 12 01681 g002

Encapsulation of Pink Pepper Essential Oil (Schinus terebinthifolius Raddi) in Albumin and Low-Methoxyl Amidated Pectin Cryogels
Abstract
:1. Introduction
2. Materials and Methods
2.1. Encapsulation of Pink Pepper Essential Oil in Cryogels
2.2. Encapsulation Efficiency (EE%)
2.3. Total Phenolic Content
2.4. Antioxidant Activity
2.5. In Vitro Antimicrobial Activity
2.6. Fourier Transform Infrared Spectrometry (FT-IR)
2.7. X-ray Diffraction
2.8. Thermal Analysis
2.9. Scanning Electron Microscopy (SEM)
2.10. Statistical Analysis
3. Results and Discussion
3.1. Encapsulation Efficiency (EE%)
3.2. Total Phenolic Compound Content and Antioxidant Activity
3.3. Antimicrobial Activity
3.4. FT-IR Spectroscopy
3.5. X-ray Diffraction
3.6. Thermal Analysis
3.7. Scanning Electron Microscopy
4. Conclusions
Author Contributions
Funding
Data Availability Statement
Acknowledgments
Conflicts of Interest
References
- Torres Neto, L.; Monteiro, M.L.G.; Mutz, Y.d.S.; Tonon, R.V.; Conte-Junior, C.A. Nanoemulsification of Essential Oil Blend by Ultrasound: Optimization of Physicochemical, Antioxidant Properties, and Activity Against Escherichia Coli. Food Bioprocess Technol. 2023. [Google Scholar] [CrossRef]
- Andrade, S.; Poncelet, D.; Ferreira, S.R.S. Sustainable Extraction and Encapsulation of Pink Pepper Oil. J. Food Eng. 2017, 204, 38–45. [Google Scholar] [CrossRef]
- Bernardi, J.L.; Ferreira, J.A.; Puton, B.M.S.; Camargo, S.D.; Dal Magro, J.; Junges, A.; Cansian, R.L.; Steffens, C.; Zeni, J.; Paroul, N. Potential Agrochemical Applications of Schinus Terebinthifolius Essential Oil. J. Stored Prod. Res. 2024, 105, 102260. [Google Scholar] [CrossRef]
- Locali-Pereira, A.R.; Lopes, N.A.; Menis-Henrique, M.E.C.; Janzantti, N.S.; Nicoletti, V.R. Modulation of Volatile Release and Antimicrobial Properties of Pink Pepper Essential Oil by Microencapsulation in Single- and Double-Layer Structured Matrices. Int. J. Food Microbiol. 2020, 335, 108890. [Google Scholar] [CrossRef]
- Dima, C.; Dima, S. Essential Oils in Foods: Extraction, Stabilization, and Toxicity. Curr. Opin. Food Sci. 2015, 5, 29–35. [Google Scholar] [CrossRef]
- Maraulo, G.E.; dos Santos Ferreira, C.; Beaufort, C.E.; Ugarte, M.G.; Mazzobre, M.F. Encapsulation of Bergamot Essential Oil Components in β-Cyclodextrin by Ultrasound-Assisted Co-Precipitation Method: Optimization, Characterization, and Antibacterial Activity. Food Bioprocess Technol. 2024. [Google Scholar] [CrossRef]
- Silva, E.K.; Fernandes, R.V.D.B.; Borges, S.V.; Botrel, D.A.; Queiroz, F. Water Adsorption in Rosemary Essential Oil Microparticles: Kinetics, Thermodynamics and Storage Conditions. J. Food Eng. 2014, 140, 39–45. [Google Scholar] [CrossRef]
- Fernandes, R.V.d.B.; Borges, S.V.; Botrel, D.A. Gum Arabic/Starch/Maltodextrin/Inulin as Wall Materials on the Microencapsulation of Rosemary Essential Oil. Carbohydr. Polym. 2014, 101, 524–532. [Google Scholar] [CrossRef] [PubMed]
- Talón, E.; Lampi, A.M.; Vargas, M.; Chiralt, A.; Jouppila, K.; González-Martínez, C. Encapsulation of Eugenol by Spray-Drying Using Whey Protein Isolate or Lecithin: Release Kinetics, Antioxidant and Antimicrobial Properties. Food Chem. 2019, 295, 588–598. [Google Scholar] [CrossRef]
- Sharif, H.R.; Goff, H.D.; Majeed, H.; Shamoon, M.; Liu, F.; Nsor-Atindana, J.; Haider, J.; Liang, R.; Zhong, F. Physicochemical Properties of β-Carotene and Eugenol Co-Encapsulated Flax Seed Oil Powders Using OSA Starches as Wall Material. Food Hydrocoll. 2017, 73, 274–283. [Google Scholar] [CrossRef]
- Dima, C.; Patrascu, L.; Cantaragiu, A.; Alexe, P.; Dima, S. The Kinetics of the Swelling Process and the Release Mechanisms of Coriandrum Sativum L. Essential Oil from Chitosan/Alginate/Inulin Microcapsules. Food Chem. 2016, 195, 39–48. [Google Scholar] [CrossRef] [PubMed]
- Locali Pereira, A.R.; Gonçalves Cattelan, M.; Nicoletti, V.R. Microencapsulation of Pink Pepper Essential Oil: Properties of Spray-Dried Pectin/SPI Double-Layer versus SPI Single-Layer Stabilized Emulsions. Colloids Surf. A Physicochem. Eng. Asp. 2019, 581, 123806. [Google Scholar] [CrossRef]
- Campelo, P.H.; Sanchez, E.A.; Fernandes, R.V.d.B.; Botrel, D.A.; Borges, S.V. Stability of Lime Essential Oil Microparticles Produced with Protein-Carbohydrate Blends. Food Res. Int. 2018, 105, 936–944. [Google Scholar] [CrossRef] [PubMed]
- Beirão da Costa, S.; Duarte, C.; Bourbon, A.I.; Pinheiro, A.C.; Serra, A.T.; Martins, M.M.; Januário, M.I.N.; Vicente, A.A.; Delgadillo, I.; Duarte, C.; et al. Effect of the Matrix System in the Delivery and in Vitro Bioactivity of Microencapsulated Oregano Essential Oil. J. Food Eng. 2012, 110, 190–199. [Google Scholar] [CrossRef]
- Hussein, A.M.S.; Mahmoud, K.F.; Hegazy, N.A.; Kamil, M.M.; Mohammad, A.A.; Mehaya, F.M. Efficiency of Micro and Nano Encapsulated Orange Peel Essential Oils on Quality of Sponge Cake. J. Environ. Sci. Technol. 2018, 12, 26–37. [Google Scholar] [CrossRef]
- Veneranda, M.; Hu, Q.; Wang, T.; Luo, Y.; Castro, K.; Madariaga, J.M. Formation and Characterization of Zein-Caseinate-Pectin Complex Nanoparticles for Encapsulation of Eugenol. LWT-Food Sci. Technol. 2018, 89, 596–603. [Google Scholar] [CrossRef]
- Ghasemi, S.; Jafari, S.M.; Assadpour, E.; Khomeiri, M. Production of Pectin-Whey Protein Nano-Complexes as Carriers of Orange Peel Oil. Carbohydr. Polym. 2017, 177, 369–377. [Google Scholar] [CrossRef] [PubMed]
- Feyzioglu, G.C.; Tornuk, F. Development of Chitosan Nanoparticles Loaded with Summer Savory (Satureja hortensis L.) Essential Oil for Antimicrobial and Antioxidant Delivery Applications. LWT-Food Sci. Technol. 2016, 70, 104–110. [Google Scholar] [CrossRef]
- Hasheminejad, N.; Khodaiyan, F.; Safari, M. Improving the Antifungal Activity of Clove Essential Oil Encapsulated by Chitosan Nanoparticles. Food Chem. 2019, 275, 113–122. [Google Scholar] [CrossRef]
- Gonçalves, N.D.; Pena, F.d.L.; Sartoratto, A.; Derlamelina, C.; Duarte, M.C.T.; Antunes, A.E.C.; Prata, A.S. Encapsulated Thyme (Thymus vulgaris) Essential Oil Used as a Natural Preservative in Bakery Product. Food Res. Int. 2017, 96, 154–160. [Google Scholar] [CrossRef]
- Gonçalves da Rosa, C.; Zapelini de Melo, A.P.; Sganzerla, W.G.; Machado, M.H.; Nunes, M.R.; Vinicius de Oliveira Brisola Maciel, M.; Bertoldi, F.C.; Manique Barreto, P.L. Application in Situ of Zein Nanocapsules Loaded with Origanum Vulgare Linneus and Thymus Vulgaris as a Preservative in Bread. Food Hydrocoll. 2020, 99, 105339. [Google Scholar] [CrossRef]
- Li, Y.; Wu, C.; Wu, T.; Wang, L.; Chen, S.; Ding, T.; Hu, Y. Preparation and Characterization of Citrus Essential Oils Loaded in Chitosan Microcapsules by Using Different Emulsifiers. J. Food Eng. 2018, 217, 108–114. [Google Scholar] [CrossRef]
- Hosseini, S.M.; Hosseini, H.; Mohammadifar, M.A.; Mortazavian, A.M.; Mohammadi, A.; Khosravi-Darani, K.; Shojaee-Aliabadi, S.; Dehghan, S.; Khaksar, R. Incorporation of Essential Oil in Alginate Microparticles by Multiple Emulsion/Ionic Gelation Process. Int. J. Biol. Macromol. 2013, 62, 582–588. [Google Scholar] [CrossRef] [PubMed]
- Noppakundilograt, S.; Piboon, P.; Graisuwan, W.; Nuisin, R.; Kiatkamjornwong, S. Encapsulated Eucalyptus Oil in Ionically Cross-Linked Alginate Microcapsules and Its Controlled Release. Carbohydr. Polym. 2015, 131, 23–33. [Google Scholar] [CrossRef] [PubMed]
- Betz, M.; García-González, C.A.; Subrahmanyam, R.P.; Smirnova, I.; Kulozik, U. Preparation of Novel Whey Protein-Based Aerogels as Drug Carriers for Life Science Applications. J. Supercrit. Fluids 2012, 72, 111–119. [Google Scholar] [CrossRef]
- Wang, J.; Li, Y.; Gao, Y.; Xie, Z.; Zhou, M.; He, Y.; Wu, H.; Zhou, W.; Dong, X.; Yang, Z.; et al. Cinnamon Oil-Loaded Composite Emulsion Hydrogels with Antibacterial Activity Prepared Using Concentrated Emulsion Templates. Ind. Crops Prod. 2018, 112, 281–289. [Google Scholar] [CrossRef]
- Kujur, A.; Kiran, S.; Dubey, N.K.; Prakash, B. Microencapsulation of Gaultheria Procumbens Essential Oil Using Chitosan-Cinnamic Acid Microgel: Improvement of Antimicrobial Activity, Stability and Mode of Action. LWT-Food Sci. Technol. 2017, 86, 132–138. [Google Scholar] [CrossRef]
- Volić, M.; Pajić-Lijaković, I.; Djordjević, V.; Knežević-Jugović, Z.; Pećinar, I.; Stevanović-Dajić, Z.; Veljović, Đ.; Hadnadjev, M.; Bugarski, B. Alginate/Soy Protein System for Essential Oil Encapsulation with Intestinal Delivery. Carbohydr. Polym. 2018, 200, 15–24. [Google Scholar] [CrossRef] [PubMed]
- Chaux-Gutiérrez, A.M.; Pérez-Monterroza, E.J.; Mauro, M.A. Rheological and Structural Characterization of Gels from Albumin and Low Methoxyl Amidated Pectin Mixtures. Food Hydrocoll. 2019, 92, 60–68. [Google Scholar] [CrossRef]
- Croguennec, T.; Nau, F.; Brulé, G. Influence of PH and Salts on Egg White Gelation. J. Food Sci. 2002, 67, 608–614. [Google Scholar] [CrossRef]
- Foegeding, E.A.; Li, H.; Bottcher, S. Gelation of Globular Proteins. In Phase/State Transition in Foods Chemical, Structural and Rheological Changes; Rao, M.A., Ed.; Marcel Dekker: New York, NY, USA, 1998; pp. 253–260. [Google Scholar]
- Haro-González, J.N.; de Alba, B.N.S.; Morales-Hernández, N.; Espinosa-Andrews, H. Type A Gelatin-Amidated Low Methoxyl Pectin Complex Coacervates for Probiotics Protection: Formation, Characterization, and Viability. Food Chem. 2024, 453, 139644. [Google Scholar] [CrossRef] [PubMed]
- Chaux-Gutiérrez, A.M.; Pérez-Monterroza, E.J.; Granda-Restrepo, D.M.; Mauro, M.A. Cryogels from Albumin and Low Methoxyl Amidated Pectin as a Matrix for Betalain Encapsulation. J. Food Process. Preserv. 2020, 44, e14843. [Google Scholar] [CrossRef]
- Abreu, F.O.M.S.; Oliveira, E.F.; Paula, H.C.B.; De Paula, R.C.M. Chitosan/Cashew Gum Nanogels for Essential Oil Encapsulation. Carbohydr. Polym. 2012, 89, 1277–1282. [Google Scholar] [CrossRef]
- Singleton, V.L.; Orthofer, R.; Lamuela-Raventós, R.M. Analysis of Total Phenols and Other Oxidation Substrates and Antioxidants by Means of Folin-Ciocalteu Reagent. Methods Enzymol. 1999, 299, 152–178. [Google Scholar] [CrossRef]
- Re, R.; Pellegrini, N.; Proteggent, A.; Pannala, A.; Yang, M.; Rice-Evans, C. Antioxidant Activity Applying an Improved ABTS Radical Cation Decolorization Assay. Free Radic. Biol. Med. 1999, 26, 1231–1237. [Google Scholar] [CrossRef]
- CLSI. Performance Standards for Antimicrobial Susceptibility Testing: 25th Informational Supplement; CLSI Document M100–S25; CLSI: Wayne, PA, USA, 2015. [Google Scholar]
- Evans, M.; Ratcliffe, I.; Williams, P.A. Emulsion Stabilisation Using Polysaccharide-Protein Complexes. Curr. Opin. Colloid Interface Sci. 2013, 18, 272–282. [Google Scholar] [CrossRef]
- Hosseini, S.F.; Zandi, M.; Rezaei, M.; Farahmandghavi, F. Two-Step Method for Encapsulation of Oregano Essential Oil in Chitosan Nanoparticles: Preparation, Characterization and in Vitro Release Study. Carbohydr. Polym. 2013, 95, 50–56. [Google Scholar] [CrossRef] [PubMed]
- Rojas-Moreno, S.; Osorio-Revilla, G.; Gallardo-Velázquez, T.; Cárdenas-Bailón, F.; Meza-Márquez, G. Effect of the Cross-Linking Agent and Drying Method on Encapsulation Efficiency of Orange Essential Oil by Complex Coacervation Using Whey Protein Isolate with Different Polysaccharides. J. Microencapsul. 2018, 35, 165–180. [Google Scholar] [CrossRef]
- Bastos, L.P.H.; dos Santos, C.H.C.; de Carvalho, M.G.; Garcia-Rojas, E.E. Encapsulation of the Black Pepper (Piper nigrum L.) Essential Oil by Lactoferrin-Sodium Alginate Complex Coacervates: Structural Characterization and Simulated Gastrointestinal Conditions. Food Chem. 2020, 316, 126345. [Google Scholar] [CrossRef]
- Chen, H.; Zhong, Q. A Novel Method of Preparing Stable Zein Nanoparticle Dispersions for Encapsulation of Peppermint Oil. Food Hydrocoll. 2015, 43, 593–602. [Google Scholar] [CrossRef]
- Rajkumar, V.; Gunasekaran, C.; Paul, C.A.; Dharmaraj, J. Development of Encapsulated Peppermint Essential Oil in Chitosan Nanoparticles: Characterization and Biological Efficacy against Stored-Grain Pest Control. Pestic. Biochem. Physiol. 2020, 170, 104679. [Google Scholar] [CrossRef] [PubMed]
- Lin, D.; Xiao, M.; Zhao, J.; Li, Z.; Xing, B.; Li, X.; Kong, M.; Li, L.; Zhang, Q.; Liu, Y.; et al. An Overview of Plant Phenolic Compounds and Their Importance in Human Nutrition and Management of Type 2 Diabetes. Molecules 2016, 21, 1374. [Google Scholar] [CrossRef] [PubMed]
- Vieira, J.d.S.; de Oliveira, V.S.; Carneiro, M.J.; da Silva, T.L.; Augusta, I.M.; de Carvalho, M.G.; Sawaya, A.C.H.F.; Saldanha, T. Phenolic Composition and Insights into the Use of Pink Pepper (Schinus terebentifolius Raddi) Fruit against Lipid Oxidation in Food Systems. Food Biosci 2023, 53, 102556. [Google Scholar] [CrossRef]
- Jia, Z.; Dumont, M.J.; Orsat, V. Encapsulation of Phenolic Compounds Present in Plants Using Protein Matrices. Food Biosci. 2016, 15, 87–104. [Google Scholar] [CrossRef]
- Chen, L.; Remondetto, G.E.; Subirade, M. Food Protein-Based Materials as Nutraceutical Delivery Systems. Trends Food Sci. Technol. 2006, 17, 272–283. [Google Scholar] [CrossRef]
- Arslan, I.; Çelik, A. Free Radical Scavenging Activities and Essential Oil Analysis of Salvia Cedronella Boiss. and S. Fruticosa Mill. J. Essent. Oil-Bear. Plants 2010, 13, 545–550. [Google Scholar] [CrossRef]
- Oliveira, K.C.; Franciscato, L.M.S.S.; Mendes, S.S.; Barizon, F.M.A.; Gonçalves, D.D.; Barbosa, L.N.; Faria, M.G.I.; Valle, J.S.; Casalvara, R.F.A.; Gonçalves, J.E.; et al. Essential Oil from the Leaves, Fruits and Twigs of Schinus Terebinthifolius: Chemical Composition, Antioxidant and Antibacterial Potential. Molecules 2024, 29, 469. [Google Scholar] [CrossRef] [PubMed]
- Dannenberg, S.; Funck, G.D.; Padilha, W.; Fiorentini, Â.M. Essential Oil from Pink Pepper (Schinus terebinthifolius Raddi): Chemical Composition, Antibacterial Activity and Mechanism of Action. Food Control 2019, 95, 115–120. [Google Scholar] [CrossRef]
- Fontes, M.R.V.; Contessa, C.R.; Moraes, C.C.; Zavareze, E.d.R.; Dias, A.R.G. Antimicrobial Properties of PLA Membranes Loaded with Pink Pepper (Schinus terebinthifolius Raddi) Essential Oil Applied in Simulated Cream Cheese Packaging. Food Biophys. 2023, 18, 107–119. [Google Scholar] [CrossRef]
- Ayari, S.; Shankar, S.; Follett, P.; Hossain, F.; Lacroix, M. Potential Synergistic Antimicrobial Efficiency of Binary Combinations of Essential Oils against Bacillus Cereus and Paenibacillus Amylolyticus-Part A. Microb. Pathog. 2020, 141, 104008. [Google Scholar] [CrossRef]
- Dannenberg, G.D.S.; Funck, G.D.; Mattei, F.J.; Da Silva, W.P.; Fiorentini, Â.M. Antimicrobial and Antioxidant Activity of Essential Oil from Pink Pepper Tree (Schinus terebinthifolius Raddi) in Vitro and in Cheese Experimentally Contaminated with Listeria Monocytogenes. Innov. Food Sci. Emerg. Technol. 2016, 36, 120–127. [Google Scholar] [CrossRef]
- Acharya, D.R.; Liu, S.; Lu, H.; Albashir, D.; Koirala, P.; Shi, Y.; Chen, Q. Nanoemulsion-Integrated Gelatin/Bacterial Cellulose Nanofibril-Based Multifunctional Film: Fabrication, Characterization, and Application. Int. J. Biol. Macromol. 2024, 257, 128341. [Google Scholar] [CrossRef]
- Laureanti, E.J.G.; Paiva, T.S.; de Matos Jorge, L.M.; Jorge, R.M.M. Microencapsulation of Bioactive Compound Extracts Using Maltodextrin and Gum Arabic by Spray and Freeze-Drying Techniques. Int. J. Biol. Macromol. 2023, 253, 126969. [Google Scholar] [CrossRef] [PubMed]
- Makshakova, O.N.; Zuev, Y.F. Interaction-Induced Structural Transformations in Polysaccharide and Protein-Polysaccharide Gels as Functional Basis for Novel Soft-Matter: A Case of Carrageenans. Gels 2022, 8, 287. [Google Scholar] [CrossRef] [PubMed]
- Liu, X.; Song, Q.; Li, X.; Chen, Y.; Liu, C.; Zhu, X.; Liu, J.; Granato, D.; Wang, Y.; Huang, J. Effects of Different Dietary Polyphenols on Conformational Changes and Functional Properties of Protein–Polyphenol Covalent Complexes. Food Chem 2021, 361, 130071. [Google Scholar] [CrossRef]
- Chen, K.; Ahmad, M.I.; Jiang, Q.; Zhang, H. Acid-Induced Hydrogels of Edible Chlorella Pyrenoidosa Protein with Composite Biopolymers Network. Food Chem. 2024, 460, 140699. [Google Scholar] [CrossRef] [PubMed]
- Sood, A.; Saini, C.S. Utilization of Peel of White Pomelo for the Development of Pectin Based Biodegradable Composite Films Blended with Casein and Egg Albumen. Food Chem. Adv. 2022, 1, 100054. [Google Scholar] [CrossRef]
- Mebarki, N.; Ziane, H.; Fazouane, F.; Nabiev, M. Microencapsulation of Thymus Fontanesii Extracts in Pectin/Casein: Characterization, Release Behavior and Storage Stability. Iran. Polym. J. 2022, 31, 301–316. [Google Scholar] [CrossRef]
- Ghobadi, M.; Koocheki, A.; Varidi, M.J.; Varidi, M. Encapsulation of Curcumin Using Grass Pea (Lathyrus sativus) Protein Isolate/Alyssum Homolocarpum Seed Gum Complex Nanoparticles. Innov. Food Sci. Emerg. Technol. 2021, 72, 102728. [Google Scholar] [CrossRef]
- Gharanjig, H.; Gharanjig, K.; Hosseinnezhad, M.; Jafari, S.M. Differential Scanning Calorimetry (DSC) of Nanoencapsulated Food Ingredients. In Characterization of Nanoencapsulated Food Ingredients; Elsevier: Amsterdam, The Netherlands, 2020; pp. 295–346. ISBN 9780128156674. [Google Scholar]
- Liu, L.; Deng, J.; Guo, S.; Li, Y.; Wang, L.; Liu, Y.; Xv, P.; Rao, Y. Stress Tolerance and Characterization of Biofilm-like Probiotic Bacteria Encapsulated in Calcium Pectin Beads. LWT 2023, 184, 115072. [Google Scholar] [CrossRef]
- Jacob, J.; Krafft, C.; Welfle, K.; Welfle, H.; Saenger, W. Melting Points of Lysozyme and Ribonucleic A Crystals Correlated with Protein Unfolding: A Raman Spectroscopic Study. Acta Crystallogr. Sect. D Biol. Crystallogr. 1998, 54, 74–80. [Google Scholar] [CrossRef] [PubMed]
- Yang, M.; Zhao, S.; Zhao, C.; Cui, J.; Wang, Y.; Fang, X.; Zheng, J. Caseinate-Reinforced Pectin Hydrogels: Efficient Encapsulation, Desirable Release, and Chemical Stabilization of (−)-Epigallocatechin. Int. J. Biol. Macromol. 2023, 230, 123298. [Google Scholar] [CrossRef] [PubMed]
- Yan, W.; Jia, X.; Zhang, Q.; Chen, H.; Zhu, Q.; Yin, L. Interpenetrating Polymer Network Hydrogels of Soy Protein Isolate and Sugar Beet Pectin as a Potential Carrier for Probiotics. Food Hydrocoll. 2021, 113, 106453. [Google Scholar] [CrossRef]

| Sample | EE (%) | Total Phenolic Content (mg GAE/g) | ABTS (μmol TEs/g) |
|---|---|---|---|
| ALB | 75.0 ± 5.5 a | 2.80 ± 0.23 a | 6.28 ± 0.49 a |
| 70:30 ALB:PEC | 75.2 ± 4.9 a | 2.31 ± 0.18 b | 1.16 ± 0.16 b |
| 50:50 ALB:PEC | 77.4 ± 1.9 a | 1.41 ± 0.11 c | 0.84 ± 0.05 b |
| 30:70 ALB:PEC | 59.6 ± 2.3 b | 0.82 ± 0.17 d | 0.99 ± 0.24 b |
| Inhibition Zone (mm) | ||||
|---|---|---|---|---|
| Mass Cryogel (mg) | ALB | 70:30 ALB:PEC | 50:50 ALB:PEC | 30:70 ALB:PEC |
| 1.25 | n.d | n.d | n.d | n.d |
| 2.5 | n.d | n.d | n.d | n.d |
| 5 | n.d | n.d | n.d | 9.33 ± 1.12 d |
| 10 | 0.50 ± 0.43 ef | n.d | 9.44 ± 0.88 d | 12.44 ± 3.54 c |
| 20 | 1.33 ± 0.50 ef | 1.89 ± 0.60 ef | 15.56 ± 1.94 b | 17.22 ± 2.59 ab |
| 30 | 1.17 ± 0.41 ef | 2.44 ± 0.73 e | 18.22 ± 1.39 a | 18.67 ± 2.83 a |
| Sample | Tpeak onset (°C) | Tpeak (°C) | Tpeak endset (°C) | ΔH (W/g) |
|---|---|---|---|---|
| ALB | 79.58 | 137.16 | 193.05 | 62.83 |
| 70:30 | 51.18 | 134.15 | 169.81 | 70.96 |
| 50:50 | 110.7 | 159.54 | 193.05 | 29.52 |
| 30:70 | 114.89 | 168.69 | 193.05 | 56.43 |
Disclaimer/Publisher’s Note: The statements, opinions and data contained in all publications are solely those of the individual author(s) and contributor(s) and not of MDPI and/or the editor(s). MDPI and/or the editor(s) disclaim responsibility for any injury to people or property resulting from any ideas, methods, instructions or products referred to in the content. |
© 2024 by the authors. Licensee MDPI, Basel, Switzerland. This article is an open access article distributed under the terms and conditions of the Creative Commons Attribution (CC BY) license (https://creativecommons.org/licenses/by/4.0/).
Share and Cite
Chaux-Gutiérrez, A.M.; Pérez-Monterroza, E.J.; Cattelan, M.G.; Nicoletti, V.R.; Moura, M.R.d. Encapsulation of Pink Pepper Essential Oil (Schinus terebinthifolius Raddi) in Albumin and Low-Methoxyl Amidated Pectin Cryogels. Processes 2024, 12, 1681. https://doi.org/10.3390/pr12081681
Chaux-Gutiérrez AM, Pérez-Monterroza EJ, Cattelan MG, Nicoletti VR, Moura MRd. Encapsulation of Pink Pepper Essential Oil (Schinus terebinthifolius Raddi) in Albumin and Low-Methoxyl Amidated Pectin Cryogels. Processes. 2024; 12(8):1681. https://doi.org/10.3390/pr12081681
Chicago/Turabian StyleChaux-Gutiérrez, Ana María, Ezequiel José Pérez-Monterroza, Marília Gonçalves Cattelan, Vânia Regina Nicoletti, and Márcia Regina de Moura. 2024. "Encapsulation of Pink Pepper Essential Oil (Schinus terebinthifolius Raddi) in Albumin and Low-Methoxyl Amidated Pectin Cryogels" Processes 12, no. 8: 1681. https://doi.org/10.3390/pr12081681
APA StyleChaux-Gutiérrez, A. M., Pérez-Monterroza, E. J., Cattelan, M. G., Nicoletti, V. R., & Moura, M. R. d. (2024). Encapsulation of Pink Pepper Essential Oil (Schinus terebinthifolius Raddi) in Albumin and Low-Methoxyl Amidated Pectin Cryogels. Processes, 12(8), 1681. https://doi.org/10.3390/pr12081681






